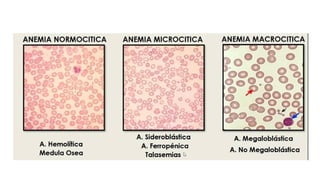

La citometría hematológica, o biometría hemática, es un examen clave que analiza tres líneas celulares: eritrocitos, leucocitos y plaquetas, proporcionando información sobre diversas patologías. Este documento detalla los valores normales y alteraciones asociadas con cada tipo de célula, incluyendo glóbulos rojos, blancos y plaquetas. Además, se abordan condiciones asociadas a la variabilidad de estos parámetros y se mencionan pruebas adicionales que complementan el análisis hematológico.